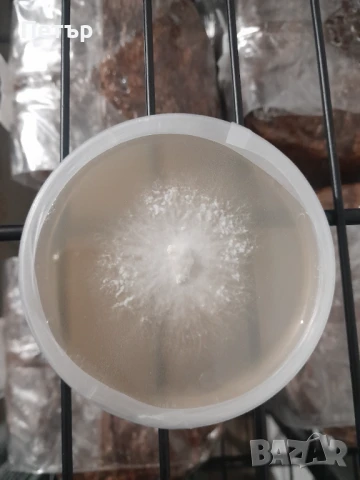
Домашно отгледани гъби Лъвска грива | Fresh Lion's Mane Mushrooms, снимка 8 - Домашни продукти - 51071668
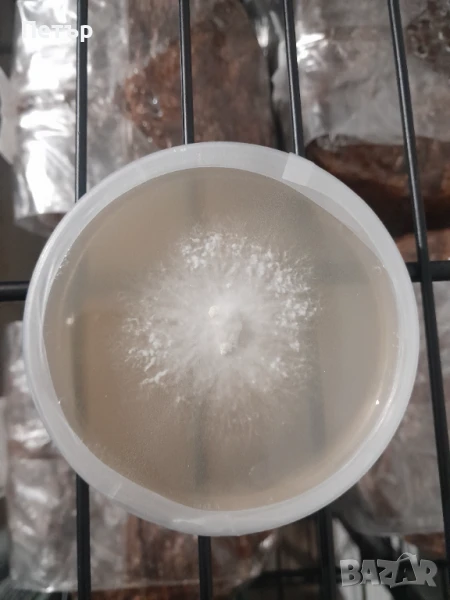

Петър
В Bazar.BG от 06 септември 2023г.
Последно активен
15 март в 14:16 ч.
Домашно отгледани гъби Лъвска грива | Fresh Lion's Mane Mushrooms → Обява 51071668
Домашно отгледани гъби Лъвска грива | Fresh Lion's Mane Mushrooms
Доставка
Продавача
Първоначално започнах да отглеждам тези гъби, защото баба ми, Бог да я прости, почина със склероза и всички изследвания които прочетох, сочат че тази гъба може да предотврати това отвратително заболяване. Отглеждам тази гъба за майка си, за себе си и за брат ми, защото силно вярвам в нейните лечебни свойства. Поради това имам само ограничени количества.
- Цената е 50лв/кг за пресни гъби. (В момента нямам пресни гъби)
- Праха е 70лв за 50гр.
- Капсулите са 500мг:
30 за 20лв
60 за 35лв
120 за 70лв + Безплатна доставка
200 за 110лв + Безплатна доставка
240 за 130лв + Безплатна доставка
300 за 150лв + Безплатна доставка
350 за 175лв + Безплатна доставка
400 за 190лв + Безплатна доставка
(Съдържат 100% органична култивирана гъбна биомаса от Hericium erinaceus (Прах от сушени гъби), без никакви пълнители.)
Моля свържете се смен, за да ви кажа дали имам налични.
Първоначално ги купувах от аптеката, но не мога да се отърва от чувството, че не знам какво има вътре в капсулите на тези фирми. Затова предпочитам да отделя парите и времето си, за да ги отглеждам сам и да съм сигурен, че това което консумирам е истинско.
Ако сте заинтересовани можете да се свържете с мен на Viber, Watsapp, Telegram или просто да се обадите. Можете също да ми оставите съобщение тук. Имам ежедневна работа, така че ако не вдигна, ще ви се обадя възможно най-скоро.
Аз самият пия една таблетка преди лягане, защото много ми помага за съня.
Ако потърсите гъбата в Google, ще видите множеството невероятни ползи за здравето които предоставя. Нищо чудно, че е обявена за една от най-лечебните гъби в света за които знаем.
Ето само някои части от тялото ни на които може да помогне и някои заболявания, за които проучванията показват че може да помогне:
-Mозъка и неговата когнитивна функция
-Нервната система като може да регенерира аксоните (нервните влакна) и нервните окончания
-Може да предпази тялото от оксидативен стрес
-Може да предложи защита срещу невродегенеративни заболявания като болестта на -Алцхаймер и деменцията
-Може да подобрят стомашно-чревния тракт и да излекува чревни язви
-Може да подпомогне изгарянето на мазнини и да подобри метаболизма
-Може да подобри здравето на сърцето, кръвообращение, стабилизира кръвната захар и да предотврати образуването на кръвни съсиреци
-Може да спомогне за поддържане на здравословен холестерол
-Може да предотврати или намали възпалителните процеси
-Може да укрепи имунната система
-Може да подпомогне спокойния сън
-Може да увеличи нивата на енергия
-Може да има противоракови свойства
- Цената е 50лв/кг за пресни гъби. (В момента нямам пресни гъби)
- Праха е 70лв за 50гр.
- Капсулите са 500мг:
30 за 20лв
60 за 35лв
120 за 70лв + Безплатна доставка
200 за 110лв + Безплатна доставка
240 за 130лв + Безплатна доставка
300 за 150лв + Безплатна доставка
350 за 175лв + Безплатна доставка
400 за 190лв + Безплатна доставка
(Съдържат 100% органична култивирана гъбна биомаса от Hericium erinaceus (Прах от сушени гъби), без никакви пълнители.)
Моля свържете се смен, за да ви кажа дали имам налични.
Първоначално ги купувах от аптеката, но не мога да се отърва от чувството, че не знам какво има вътре в капсулите на тези фирми. Затова предпочитам да отделя парите и времето си, за да ги отглеждам сам и да съм сигурен, че това което консумирам е истинско.
Ако сте заинтересовани можете да се свържете с мен на Viber, Watsapp, Telegram или просто да се обадите. Можете също да ми оставите съобщение тук. Имам ежедневна работа, така че ако не вдигна, ще ви се обадя възможно най-скоро.
Аз самият пия една таблетка преди лягане, защото много ми помага за съня.
Ако потърсите гъбата в Google, ще видите множеството невероятни ползи за здравето които предоставя. Нищо чудно, че е обявена за една от най-лечебните гъби в света за които знаем.
Ето само някои части от тялото ни на които може да помогне и някои заболявания, за които проучванията показват че може да помогне:
-Mозъка и неговата когнитивна функция
-Нервната система като може да регенерира аксоните (нервните влакна) и нервните окончания
-Може да предпази тялото от оксидативен стрес
-Може да предложи защита срещу невродегенеративни заболявания като болестта на -Алцхаймер и деменцията
-Може да подобрят стомашно-чревния тракт и да излекува чревни язви
-Може да подпомогне изгарянето на мазнини и да подобри метаболизма
-Може да подобри здравето на сърцето, кръвообращение, стабилизира кръвната захар и да предотврати образуването на кръвни съсиреци
-Може да спомогне за поддържане на здравословен холестерол
-Може да предотврати или намали възпалителните процеси
-Може да укрепи имунната система
-Може да подпомогне спокойния сън
-Може да увеличи нивата на енергия
-Може да има противоракови свойства
Преглеждания: 250
Моля, следете за наличието/липсата на документ удостоверяващ вписването в регистрите съобразно Закона за храните към всяка обява!
Другите търсят също
Вход
Регистрация
Влез в профила си или се регистрирай, за да не губиш наблюдаваните обяви, търсенията си и следваните потребители – ще ги имаш навсякъде с теб.
Вход/Регистрация